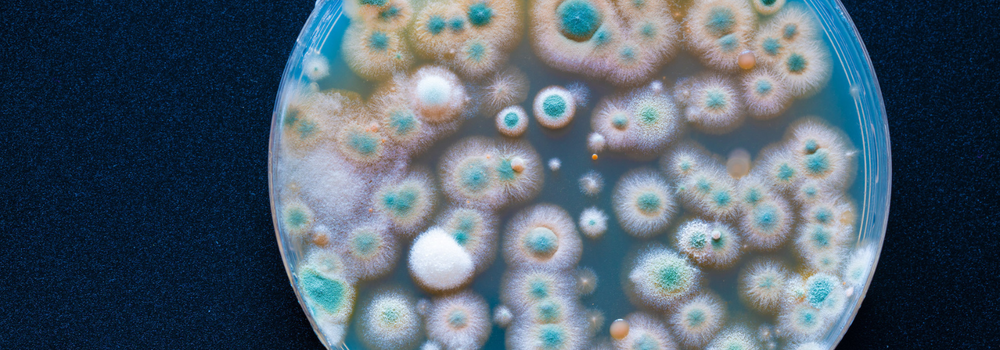

One of our Social Microbes residents, Hat Porter has the following request for input into their residency project:
'If you are autistic, I’d love for you to answer 2 quick questions about how you feel about research on autism and microbes and what your priorities for autism research are".
You can find the form here, it is nice and short!
Hat will be making artwork incorporating and responding to everyone's thoughts and input.